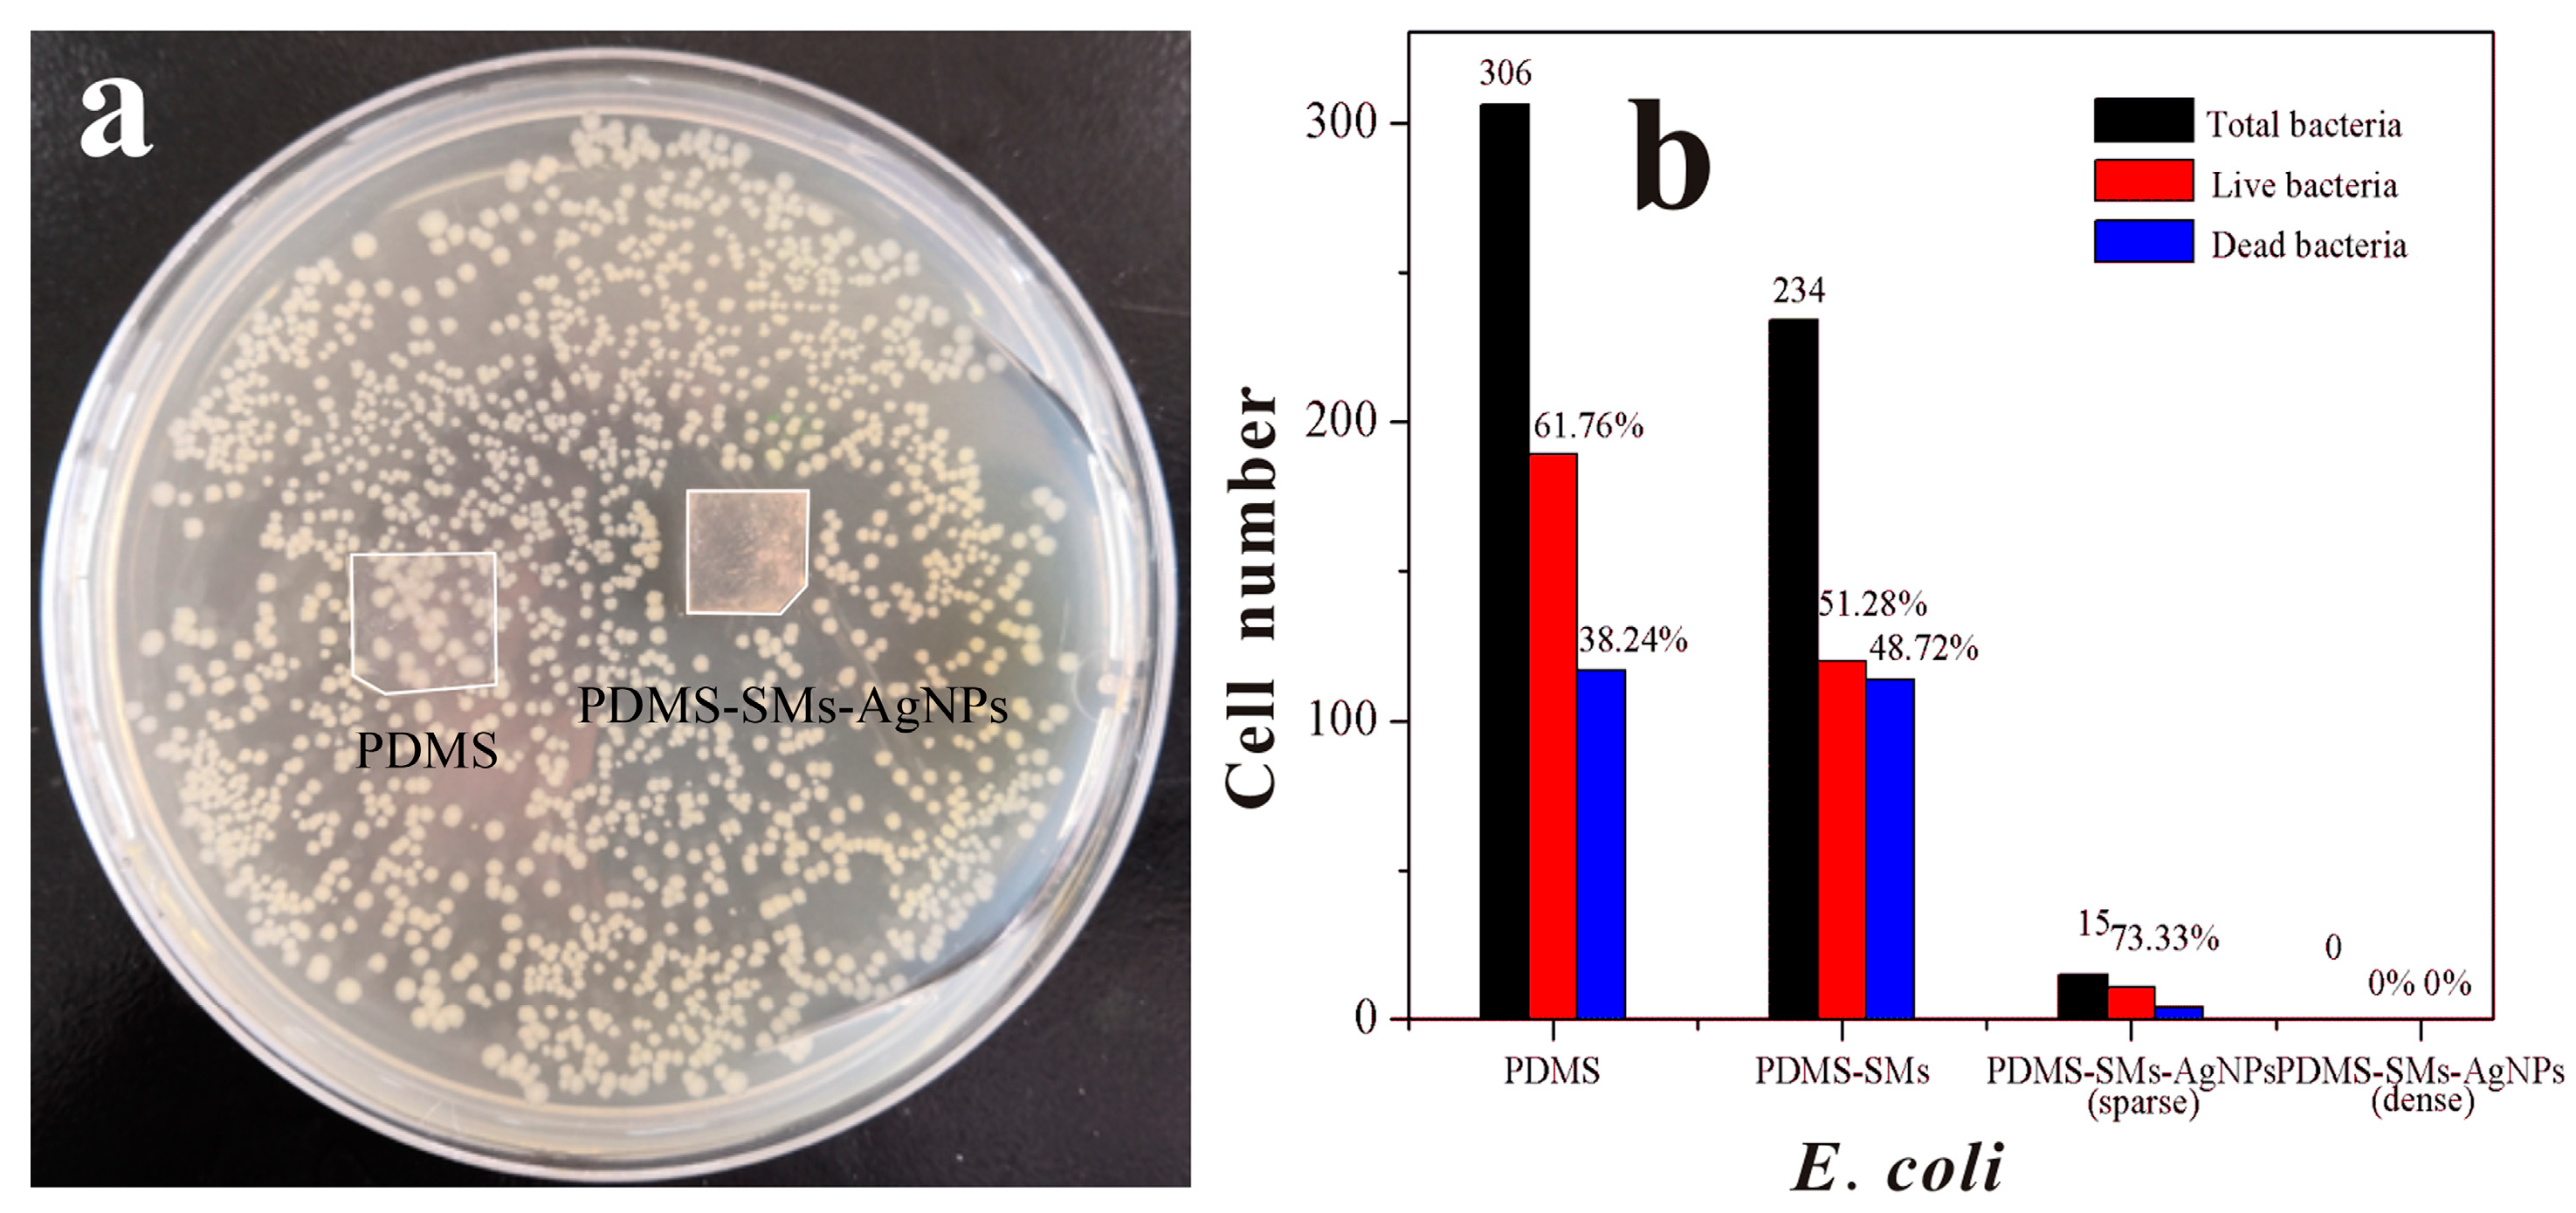
Nanomaterials 09 00705 g004 Nanomaterials 09 00705 g004

Enhanced Antibacterial Activity of Poly (dimethylsiloxane) Membranes by Incorporating SiO2 Microspheres Generated Silver Nanoparticles
Abstract
1. Introduction
2. Materials and Methods
2.1. Materials
2.2. Synthesis of AgNPs on the Surface of PDMS which Assembled with SiO2 Microspheres
2.2.1. Surface of PDMS Modified with Ene Group
2.2.2. Synthesis of SMs Functionalized with Thiol Groups
2.2.3. Assemblies of SMs on the Surface of PDMS (PDMS-SMs) by Light Click Chemistry Reaction
2.2.4. Synthesis of AgNPs on the Surface of PDMS-SMs (PDMS-SMs-AgNPs)
2.3. Characterization of Samples
2.4. Study of Antibacterial Activity
3. Results and Discussion
3.1. Characterization
3.2. Antimicrobial Efficiency
4. Conclusions
Supplementary Materials
Author Contributions
Funding
Conflicts of Interest
References
- Berean, K.J.; Adetutu, E.M.; Ou, J.Z.; Nour, M.; Nguyen, E.P.; Paull, D.; Mcleod, J.; Ramanathan, R.; Bansal, V.; Latham, K.; et al. A unique in vivo approach for investigating antimicrobial materials utilizing fistulated animals. Sci. Rep. 2015, 5, 11515. [Google Scholar] [CrossRef]
- Lamberti, A.; Virga, A.; Rivolo, P.; Angelini, A.; Giorgis, F. Easy tuning of surface and optical properties of PDMS decorated by Ag nanoparticles. J. Phys. Chem. B 2015, 119, 8194–8200. [Google Scholar] [CrossRef] [PubMed]
- Pouget, E.; Tonnar, J.; Lucas, P.; Lacroix-Desmazes, P.; Ganachaud, F.; Boutevin, B. Well-architectured poly(dimethylsiloxane)-containing copolymers obtained by radical chemistry. Chem. Rev. 2010, 110, 1233–1277. [Google Scholar] [CrossRef] [PubMed]
- Bee, M.Y.; Jastrzembski, J.A.; Sacks, G.L. Parallel headspace extraction onto etched sorbent sheets prior to ambient-ionization mass spectrometry for automated; trace-level volatile analyses. Anal. Chem. 2018, 90, 13806–13813. [Google Scholar] [CrossRef] [PubMed]
- Bian, X.; Lan, Y.; Wang, B.; Zhang, Y.S.; Liu, B.; Yang, P.; Zhang, W.; Qiao, L. Microfluidic Air Sampler for Highly Efficient Bacterial Aerosol Collection and Identification. Anal. Chem. 2016, 88, 11504–11512. [Google Scholar] [CrossRef]
- Ahmed, D.; Ozcelik, A.; Bojanala, N.; Nama, N.; Upadhyay, A.; Chen, Y.; Hanna-Rose, W.; Huang, T.J. Rotational manipulation of single cells and organisms using acoustic waves. Nat. Commun. 2016, 7, 11085. [Google Scholar] [CrossRef]
- Sun, J.; Zhou, W.; Yang, H.; Zhen, X.; Ma, L.; Williams, D.; Sun, X.; Lang, M. Highly transparent and flexible circuits through patterning silver nanowires into microfluidic channels. Chem. Commun. 2018, 54, 4923–4926. [Google Scholar] [CrossRef]
- Liang, X.; Peng, L.; Zhang, S.; Zhou, S.; Yoshida, A.; Osatomi, K.; Bellou, N.; Guo, X.; Dobretsov, S.; Yang, J. Polyurethane; epoxy resin and polydimethylsiloxane altered biofilm formation and mussel settlement. Chemosphere 2019, 218, 599–608. [Google Scholar] [CrossRef]
- Azimi, H.; Tezel, F.H.; Thibault, J. Effect of embedded activated carbon nanoparticles on the performance of polydimethylsiloxane (PDMS) membrane for pervaporation separation of butanol. J. Chem. Technol. Biot. 2017, 92, 2901–2911. [Google Scholar] [CrossRef]
- Liu, G.; Zhou, T.; Liu, W.; Hu, S.; Pan, F.; Wu, H.; Jiang, Z.; Wang, B.; Yang, J.; Cao, X. Enhanced desulfurization performance of PDMS membranes by incorporating silver decorated dopamine nanoparticles. J. Mater. Chem. A 2014, 2, 12907–12917. [Google Scholar] [CrossRef]
- Yin, J.; Yang, Y.; Hu, Z.; Deng, B. Attachment of silver nanoparticles (AgNPs) onto thin-film composite (TFC) membranes through covalent bonding to reduce membrane biofouling. J. Membrane. Sci. 2013, 441, 73–82. [Google Scholar] [CrossRef]
- Chang, H.; Tu, K.; Wang, X.; Liu, J. Fabrication of mechanically durable superhydrophobic wood surfaces using polydimethylsiloxane and silica nanoparticles. RSC Adv. 2015, 5, 30647–30653. [Google Scholar] [CrossRef]
- Álvarez-Paino, M.; Muñoz-Bonilla, A.; Fernández-García, M. Antimicrobial Polymers in the Nano-World. Nanomaterials 2017, 7, 48. [Google Scholar] [CrossRef] [PubMed]
- Muñoz-Bonilla, A.; Fernández-García, M. The roadmap of antimicrobial polymeric materials in macromolecular nanotechnology. Eur. Polym. J. 2015, 65, 46–62. [Google Scholar] [CrossRef]
- Campoccia, D.; Montanaro, L.; Arciola, C.R. A review of the biomaterials technologies for infection-resistant surfaces. Biomaterials 2013, 34, 8533–8554. [Google Scholar] [CrossRef]
- Uppu, D.S.; Smaddar, S.; Ghosh, C.; Paramanandham, K.; Shome, B.R.; Haldar, J. Amide side chain amphiphilic polymers disrupt surface established bacterial bio-films and protect mice from chronic Acinetobacter baumannii infection. Biomaterials 2016, 74, 131–143. [Google Scholar] [CrossRef]
- Ivask, A.; ElBadawy, A.; Kaweeteerawat, C.; Boren, D.; Fischer, H.; Ji, Z.; Chang, C.H.; Liu, R.; Tolaymat, T.; Telesca, D.; et al. Toxicity mechanisms in Escherichia coli vary for silver nanoparticles and differ from ionic silver. ACS Nano 2014, 8, 374–386. [Google Scholar] [CrossRef] [PubMed]
- Gilabert-Porres, J.; Martí, S.; Calatayud, L.; Ramos, V.; Rosell, A.; Borrós, S. Design of a nanostructured active surface against Gram-positive and Gram-negative bacteria through plasma activation and in situ silver reduction. ACS Appl. Mater. Interfaces 2016, 8, 64–73. [Google Scholar] [CrossRef]
- Gallo, J.; Panacek, A.; Prucek, R.; Kriegova, E.; Hradilova, S.; Hobza, M.; Holinka, M. Silver nanocoating technology in the prevention of prosthetic joint infection. Materials 2016, 9, 337. [Google Scholar] [CrossRef]
- Jia, Z.; Xiu, P.; Li, M.; Xu, X.; Shi, Y.; Cheng, Y.; Wei, S.; Zheng, Y.; Xi, T.; Cai, H.; et al. Bioinspired anchoring AgNPs onto micro-nanoporous TiO2 orthopedic coatings: Trap-killing of bacteria; surface-regulated osteoblast functions and host responses. Biomaterials 2016, 75, 203–222. [Google Scholar] [CrossRef] [PubMed]
- Guo, Q.; Zhao, Y.; Dai, X.; Zhang, T.; Yu, Y.; Zhang, X.; Li, C. Functional Silver Nanocomposites as Broad-Spectrum Antimicrobial and Biofilm-Disrupting Agents. ACS Appl. Mater. Interfaces 2017, 9, 16834–16847. [Google Scholar] [CrossRef] [PubMed]
- Yu, K.; Lu, F.; Li, Q.; Chen, H.; Lu, B.; Liu, J.; Li, Z.; Dai, F.; Wu, D.; Lan, G. In situ assembly of Ag nanoparticles (AgNPs) on porous silkworm cocoon-based wound film: Enhanced antimicrobial and wound healing activity. Sci. Rep. 2017, 7, 2017. [Google Scholar] [CrossRef]
- Tulve, N.S.; Stefaniak, A.B.; Vance, M.E.; Rogers, K.; Mwilu, S.; LeBouf, R.F.; Schwegler-Berry, D.; Willis, R.; Thomas, T.A.; Marr, L.C. Characterization of silver nanoparticles in selected consumer products and its relevance for predicting children’s potential exposures. Int. J. Hyg. Environ. Health 2015, 218, 345–357. [Google Scholar] [CrossRef]
- Brennan, S.A.; Ní Fhoghlú, C.; Devitt, B.M.; O’Mahony, F.J.; Brabazon, D.; Walsh, A. Silver nanoparticles and their orthopaedic applications. Bone Joint J. 2015, 97B, 582–589. [Google Scholar] [CrossRef]
- Taglietti, A.; Arciola, C.R.; D’Agostino, A.; Dacarro, G.; Montanaro, L.; Campoccia, D.; Cucca, L.; Vercellino, M.; Poggi, A.; Pallavicini, P.; et al. Antibiofilm activity of a monolayer of silver nanoparticles anchored to an amino-silanized glass surface. Biomaterials 2014, 35, 1779–1788. [Google Scholar] [CrossRef]
- Liu, Y.; Li, Y.; Kang, Y.; Shen, Q.; Liu, X.; Zhou, J. Silver nanoparticle generators: Silicon dioxide microspheres. Chem. Eur. J. 2017, 23, 6244–6248. [Google Scholar] [CrossRef] [PubMed]
- Liu, C.Y.; Huang, C.J. Functionalization of polydopamine via the Aza-Michael reaction for antimicrobial interfaces. Langmuir 2016, 32, 5019–5028. [Google Scholar] [CrossRef]
- Wong, I.; Ho, C.M. Surface molecular property modifications for poly(dimethylsiloxane) (PDMS) based microfluidic devices. Microfluid Nanofluid 2009, 7, 291. [Google Scholar] [CrossRef]
- Jiang, Y.; O’Neill, A.J.; Ding, Y. Zinc oxide nanoparticle-coated films: Fabrication, characterization, and antibacterial properties. J. Nanopart. Res. 2015, 17, 180. [Google Scholar] [CrossRef]
- Cui, J.H.; Liang, Y.; Yang, D.S.; Liu, Y. Facile fabrication of rice husk based silicon dioxide nanospheres loaded with silver nanoparticles as a rice antibacterial agent. Sci. Rep. 2016, 6, 21423. [Google Scholar] [CrossRef]
- Zheng, Y.; Miao, J.; Zhang, F.; Cai, C.; Koh, A.; Simmons, T.J.; Mousa, S.A.; Linhardt, R. Surface modification of a polyethylene film for anticoagulant and antimicrobial catheter. React. Funct. Polym. 2016, 100, 142–150. [Google Scholar] [CrossRef] [PubMed]
- Jiang, J.; Fu, Y.; Zhang, Q.; Zhan, X.; Chen, F. Novel amphiphilic poly(dimethylsiloxane) based polyurethane networks tethered with carboxybetaine and their combined antibacterial and anti-adhesive property. Appl. Surf. Sci. 2017, 412, 1–9. [Google Scholar] [CrossRef]
- Zhang, B.; Liu, B.; Deng, X.; Cao, S.; Hou, X.; Chen, H. A novel approach for the preparation of organic-siloxane oligomers and the creation of hydrophobic surface. Appl. Surf. Sci. 2007, 254, 452–458. [Google Scholar] [CrossRef]
- Teng, M.; Wang, H.; Li, F.; Zhang, B. Thioether-functionalized mesoporous fiber membranes: Sol–gel combined electrospun fabrication and their applications for Hg2+ removal. J. Colloid. Interfaces Sci. 2011, 355, 23–28. [Google Scholar] [CrossRef]
- Erdemir, A.; Nilufer, I.B.; Eryilmaz, O.L.; Beschliesser, M.; Fenske, G.R. Friction and wear performance of diamond-like carbon films grown in various source gas plasmas. Surf. Coat. Technol. 1999, 120–121, 589–593. [Google Scholar] [CrossRef]
- Loher, S.; Schneider, O.D.; Maienfisch, T.; Bokorny, S.; Stark, W.J. Micro-organism-triggered release of silver nanoparticles from biodegradable oxide carriers allows preparation of self-sterilizing polymer surfaces. Small 2008, 4, 824–832. [Google Scholar] [CrossRef] [PubMed]
- Hua, N.Y.; Chang, Y.; Feng, S. Kinetics Study of Silver Electrocrystallization on (3-mercaptopropyl) trimethoxysilane-grafted Indium Tin Oxide Plastic. Electrochim. Acta 2015, 158, 121–128. [Google Scholar]
- Morita, T.; Kimura, S. Long-Range Electron Transfer over 4 nm Governed by an Inelastic Hopping Mechanism in Self-Assembled Monolayers of Helical Peptides. J. Am. Chem. Soc. 2003, 125, 8732–8733. [Google Scholar] [CrossRef] [PubMed]
- Da Silva, R.R.; Yang, M.; Choi, S.; Chi, M.; Luo, M.; Zhang, C.; Li, Z.; Camargo, P.H.C.; Ribeiro, S.J.L.; Xia, Y. Facile synthesis of sub-20 nm silver nanowires through a bromide-mediated polyol method. ACS Nano 2016, 10, 7892–7900. [Google Scholar] [CrossRef] [PubMed]
- Yang, P.; Xu, Y.; Chen, L.; Wang, X.; Mao, B.; Me, Z.; Wang, S.; Bao, F.; Zhang, Q. Encapsulated silver nanoparticles can be directly converted to silver nanoshell in the gas phase. Nano Lett. 2015, 15, 8397–8401. [Google Scholar] [CrossRef] [PubMed]
- Shao, W.; Liu, X.; Min, H.; Dong, G.; Feng, Q.; Zuo, S. Preparation; characterization; and antibacterial activity of silver nanoparticle-decorated graphene oxide nanocomposite. ACS Appl. Mater. Interfaces 2015, 7, 6966–6973. [Google Scholar] [CrossRef] [PubMed]
- Nie, C.; Yang, Y.; Cheng, C.; Ma, L.; Deng, J.; Wang, L.; Zhao, C. Bioinspired and biocompatible carbon nanotube-Ag nanohybrid coatings for robust antibacterial applications. Acta Biomater. 2017, 51, 479–494. [Google Scholar] [CrossRef] [PubMed]

| Agent | Silver Dosage (μg/cm2) | ZOI (diameter, cm) | ZOI/Dosage (cm3/μg) | Ref. | ||
|---|---|---|---|---|---|---|
| E. coli | B. subtilis | E. coli | B. subtilis | |||
| Ag/ZnO | 10455 | 2.3 ± 0.06 | 2.5 ± 0.12 | 2.2 × 10−4 | 2.4 × 10−4 | [1] |
| AgNPs/ Coffea extract | 1892 | 3.1 | 2.7 | 1.6 × 10−3 | 1.4 × 10−3 | [2] |
| Silver Catheter | - | No ZOI | 0.73 ± 0.21 | - | - | [3] |
| Dopa-PAA/PEI-0.05AgNPs | 128 | - | 0.26 ± 0.04 | - | 1.8 × 10−3 | [5] |
| AgNPs/ PCL/PDMAEMA | 126 | 1.02 | - | 8.2×10−3 | - | [6] |
| AgNPs@oCNT-Nanohybrid | 77 | 0.51 | - | 6.6 × 10−3 | - | [42] |
| PDMS- SMs-AgNPs | 14.5 | 0.98 ± 0.02 | 1.16 ± 0.04 | 6.7 × 10−2 | 8.0 × 10−2 | This work |
© 2019 by the authors. Licensee MDPI, Basel, Switzerland. This article is an open access article distributed under the terms and conditions of the Creative Commons Attribution (CC BY) license (http://creativecommons.org/licenses/by/4.0/).
Share and Cite
Shen, Q.; Shan, Y.; Lü, Y.; Xue, P.; Liu, Y.; Liu, X. Enhanced Antibacterial Activity of Poly (dimethylsiloxane) Membranes by Incorporating SiO2 Microspheres Generated Silver Nanoparticles. Nanomaterials 2019, 9, 705. https://doi.org/10.3390/nano9050705
Shen Q, Shan Y, Lü Y, Xue P, Liu Y, Liu X. Enhanced Antibacterial Activity of Poly (dimethylsiloxane) Membranes by Incorporating SiO2 Microspheres Generated Silver Nanoparticles. Nanomaterials. 2019; 9(5):705. https://doi.org/10.3390/nano9050705
Chicago/Turabian StyleShen, Qihui, Yixuan Shan, Yang Lü, Peng Xue, Yan Liu, and Xiaoyang Liu. 2019. "Enhanced Antibacterial Activity of Poly (dimethylsiloxane) Membranes by Incorporating SiO2 Microspheres Generated Silver Nanoparticles" Nanomaterials 9, no. 5: 705. https://doi.org/10.3390/nano9050705
APA StyleShen, Q., Shan, Y., Lü, Y., Xue, P., Liu, Y., & Liu, X. (2019). Enhanced Antibacterial Activity of Poly (dimethylsiloxane) Membranes by Incorporating SiO2 Microspheres Generated Silver Nanoparticles. Nanomaterials, 9(5), 705. https://doi.org/10.3390/nano9050705

